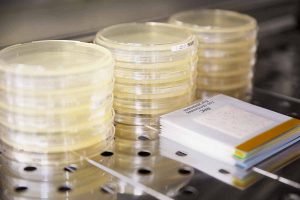

E INDUSTRIA
SEGURIDAD

El MC MEDIA PAD® es un método alternativo a la microbiología tradicional, un método rápido y fácil, para la evaluación de la contaminación microbiana de los alimentos y bebidas. ¿Y para que sirve?

El MC MEDIA PAD® es un dispositivo de cultivo seco pre esterilizado, listo para usar, que simplifica las pruebas y minimiza la cantidad de desechos respecto a las placas de petri. ¿Cómo está compuesto y cómo se usa?MC MEDIA PAD® se compone de una lámina adhesiva única, una almohadilla de prueba recubierta con medio y un polímero que absorbe el exceso de agua y de una película transparente para reconstituir automáticamente el medio. El MC MEDIA PAD® está recubierto con un medio selectivo y sustrato cromogénico para la detección específica. Una vez que la muestra líquida se inocula en la almohadilla de prueba, la muestra difunde por toda la almohadilla por acción capilar. ¿Porqué es tu mejor opción?

¿Y qué opciones tenemos?

MC-Media Pad® está disponible para la detección de Escherichia Coli, levadura y moho, coliformes o contaminación microbiana aerobia total.

COLIFORMES – Fácil lectura gracias a las colonias de color azul.

COLIFORMES Y E. COLI – Enfoque cromogénico, fácil diferenciación entre E. coli y colonias coliformes además no se requiere formación de gases.

RECUENTO DE AEROBIOS – Poco tiempo para el resultado.Incubación: 35 ° C, 24 horas.

HONGOS Y LEVADURAS – El tiempo para obtener resultados en varias matrices es de 48 horas, el área de muestra es adecuada para evitar la propagación de los HONGOS y garantizar una lectura válida. Incubación: 25 °C, 48 horas.





Tambíen se puede usar para control de higiene, apoyando el dedo sobre la zona reactiva o exponiendo la almohadilla al ambiente.


¿Quieres saber más? solicita información a graciela.martinez@tecnicadelplata.com.uyTambién puedes ver este video donde verás claramente cómo se usa:https://www.sigmaaldrich.com/technical-documents/articles/microbiology/color-coded-mc-media-pads.html